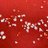

音楽劇
音楽劇
星の王子さま
実演鑑賞
東京芸術劇場 シアターイースト(東京都)
2020/02/08 (土) ~ 2020/02/12 (水) 公演終了
上演時間:
公式サイト:
https://www.geigeki.jp/performance/theater231/
公演詳細
| 期間 | 2020/02/08 (土) ~ 2020/02/12 (水) |
|---|---|
| 劇場 | 東京芸術劇場 シアターイースト |
| 出演 | 昆夏美、伊礼彼方、廣川三憲(ナイロン100℃)、吉田萌美、内田靖子、岡野一平、平山トオル、原田智子、沼舘美央、大内慶子、堀江葵月 |
| 脚本 | 青木豪 |
| 演出 | 青木豪 |
| 料金(1枚あたり) |
6,000円 ~ 6,000円 【発売日】2019/11/16 全席指定・税込 6,000円 ※未就学児童のご入場はご遠慮ください。 ※やむを得ない事情により、出演者等が変更となる場合があります。あらかじめご了承ください。 |
| 公式/劇場サイト | ※正式な公演情報は公式サイトでご確認ください。 |
| タイムテーブル | 2月8日(土) 17:00 2月9日(日) 13:00 / 17:00★ 2月10日(月) 19:00★ 2月11日(火) 13:00 / 17:00◆ 2月12日(水) 14:00 開場:開演の30分前 ★:終演後にアフタートークあり(出演:昆夏美 伊礼彼方 廣川三憲) ◆:追加公演 |
| 説明 | 世界的ベストセラーの名作 昆夏美・伊礼彼方を主軸に待望の再演! 幅広い年齢層の方々に支持される世界的ベストセラー作品「星の王子さま」。この作品を青木豪ならではの音楽劇として創造、ピアニストが薔薇役も担う独特の演出プランで展開した本作が、笠松泰洋による耳と心に残る楽曲と共に、待望の再演の機会を迎えます。 今年「レ・ミゼラブル」のジャベール役(伊礼彼方)とエポニーヌ役(昆夏美)でも共演、大絶賛を浴びたミュージカル界注目の二人が主軸の音楽劇、昆夏美が王子さま、伊礼彼方が飛行士を演じる「星の王子さま」に改めてご注目を!オリンピックイヤーの2020年、更に進化した音楽劇「星の王子さま」をお届け致します。人それぞれの感動があり、必ずや心豊かになるパワースポットのような音楽劇です! |
| その他注意事項 | ※未就学児童のご入場はご遠慮ください。 |
| スタッフ | 原作:アントワーヌ・ド・サン=テグジュペリ 作曲・音楽監督:笠松泰洋 ピアノ演奏・薔薇:松木詩奈 コントラバス演奏:小美濃悠太 内田義範(2/10~12) |
この公演に関するツイート
初日1週間前から「団体名」と「公演タイトル」を含むツイートを自動表示します。
(ツイート取得対象にするテキストは公演情報編集ページで設定できます。)
-
2/20 BOOK ACT 朗読劇 チケット お譲り致します。 19時~ C~D列 1枚 センターブロック 希望額明記の上DMお願い致します。 兵庫県立芸術文化センター 無理なお値段等お返事致しません。
6年以上前
-
BOOK ACT 朗読劇 もう一度君と踊りたい 兵庫県立芸術文化センター 譲:2/20 19:00 2階A〜C列 お求めの方は希望額記載の上DMよろしくお願いします。 https://t.co/e3RKRMfuCs #BOOKACT #ブックアクト #藤原樹 #長谷川慎
6年以上前
-
朗読劇 BOOK ACT 「もう一度君と踊りたい」 譲)兵庫県立芸術文化センター 2/20 19時公演 1連 1階席 N~Q 通路側 お心あたりのある方は金額明記のうえDMへお願いします🙏🏻… https://t.co/o1Yw4lw7YL
6年以上前
-
<拡散希望> チケットお譲りします。 BOOK ACT もう一度君と踊りたい 2/19 14時 兵庫県立芸術文化センター ・1枚 1組 ・2連番 1組 ご希望の方はDMお願いします。
6年以上前
-
音楽劇、星の王子さまを観てきました。 原作は若い頃、一度読んだ事があって、その時はよく分からなかったけど、今回の劇では胸にスッと入ってくるものがありましたねえ。 役者さんのパワーも凄かったし、生演奏の音楽も良かった。 堀江葵月ちゃ… https://t.co/ouWnlt3fj8
6年以上前
-
@jsbryu_generyu おかんさん色々情報ありがとうございます😭 行きは夜行でのんびり行くんですが 兵庫県立芸術文化センターが未知過ぎて😓 上司に伝えて夜行で帰ってそのまま 出勤にします😂
6年以上前
-
いつも買って満足してしまうのでパラパラ程度であまり読まないんだけど、音楽劇 星の王子さまのパンフレットは珍しく読んだ😅 アンサンブルさんから見る伊礼さんの存在がとても大きい事がわかって……素敵すぎて……どーしましょ😂
6年以上前
-
宝塚大劇場から素早く移動して 兵庫県立芸術文化センターで 「 さん、 さん、 さん 3人の再演キャストが相変わらず素晴らしくて トークショーもあり楽しかった!! 本当にいい作品、… https://t.co/yHg7YeOham #星の王子さま #伊礼彼方 #昆夏美 #廣川三憲
6年以上前
-
朗読劇 BOOKACT 「もう一度君と踊りたい」 兵庫県立芸術文化センター 【譲】2/19 14:00 1階L列 1枚 【求】2/19 19:00 1階席(詳細はDM) 1枚 14:00の開演に間に… https://t.co/ai2Q2JT3nN
6年以上前
-
音楽劇「星の王子さま」観てきました 感想は長文になりそうだから割愛 ここ数年色々と舞台も観てますが、音楽劇っていうのもいいですね 堀江葵月ちゃんが出演していなければ出会えなかった舞台 きーちゃん、ありがとう 久しぶりに素敵なお… https://t.co/cLdytpW0HT
6年以上前
-
明日は。 音楽劇『星の王子さま』観劇 友達の誕プレ買う ポイントで本買う
6年以上前
-
川田洋之助(@zVMJctKlET3AYQV)さんことペッショリーノ川田氏がボーカルをつとめる「金魚スピリト組」が『DREAM ENERGY in兵庫』に出演決定だそうです。 日時:2020年4月3日(金) 場所:兵庫県立芸術文化… https://t.co/HPzVzev7hy
6年以上前
-
川田洋之助(@zVMJctKlET3AYQV)さんことペッショリーノ川田氏がボーカルをつとめる「金魚スピリト組」が『DREMENERGY』に出演決定だそうです。 日時:2020年4月3日(金) 場所:兵庫県立芸術文化センター 料金… https://t.co/ubk3wo2qJ2
6年以上前
-
音楽劇『星の王子さま』観劇 大内慶子さまご出演。小柄な彼女のパッションと愛を感じて帰路。すてきな座組。飛行士と王子が鏡写しになって、物語は進む。客席は大盛り上がり。ぼくもしっかり落涙(笑) ああ、楽しかった‼️素敵な時間をあり… https://t.co/H5WR5ax9Of
6年以上前
-
【拡散希望】 BOOK ACT 02/22 19:00 兵庫県立芸術文化センター 譲ります。返金保証つきのチケットストリートから取引をお願いします! https://t.co/9BPGET0Ul7 @ticketstより #朗読劇 #チケット #チケスト
6年以上前
-
今日は、星は星でも、西宮の兵庫県立芸術文化センター『 』に行ってきました。 トークショーもあって、とっても楽しめました。 とってもとっても素敵な公演でした🌟 https://t.co/Fx1gb0OFCY #星の王子さま
6年以上前
-
音楽劇 星の王子さまを観てきました~!そうです、ここまでに読破しておきたかったのです。読み始めてたらたまたま舞台があることを知りそれがたまたま青木豪さんだったので…これは観に行かなくてはと。すごくよかった…!本が立体になってる…!でも時々ヘンで青木豪さんの世界…
6年以上前
-
ふふふ、兵庫県立芸術文化センターがあったよ……佐渡さんのホームグラウンドだったよ……
6年以上前
-
朗読劇 BOOK ACT 【求】2/20 兵庫県立芸術文化センター 1階席 1連 【譲】定価+手数料+送料 ⚠️相場理解してないです トラブル回避のためチケットサイトなどを… https://t.co/zy5pJkMJ2w
6年以上前
-
BOOK ACT 朗読劇 「 もう一度君と踊りたい 」 兵庫県立芸術文化センター 求)2/20 19:00〜 1連 1枚 席は気にしません! FCから一般まで全滅しました… どうしても母を連れて行きたいので譲って下さる方いら… https://t.co/gWZss2SmpZ
6年以上前
-
朗読劇 BOOK ACT もう一度君と踊りたい 2月20日 時間は問いません 【求】2/20 兵庫 兵庫県立芸術文化センター 1階席 上手側 1連 定価〜1.4程度で求めており… https://t.co/DH4Q06r9bO
6年以上前
-
朗読劇 bookact「もう一度君と踊りたい」 【譲】兵庫県立芸術文化センター 2/19 2月19日(水) 1連 1階席 希望額記入の上DMお願い致します🙇♀️ #BOOKACT #もう一度君と踊りたい #朗読劇
6年以上前
-
LDH BOOKACT 朗読劇 芸人交換日記 2/22 14時から 兵庫県立芸術文化センター チケット1枚余ってます! 3500円でお譲り可能です💦⭕️ FC枠の紙チケットで重複分ではないです。仕事の都合で行けなくなりまし… https://t.co/8HDD82eJLx
6年以上前
-
BOOK ACT 朗読劇 もう一度君と踊りたい 兵庫県立芸術文化センター 【譲】2/20 19:00 O列10~15番 1枚 1.6〜/即決1.9 お求めの方は希望額記載の上DMよろしくお願いします。 https://t.co/Gu8ivwuAvM #BOOKACT
6年以上前
-
令和2年初の舞台観劇は、堀江葵月ちゃんが出演する音楽劇「星の王子さま」 ハロプロ研修生の活動が終わっても活躍してくれるのは嬉しいね 音楽劇っていうのは初めてなんだけど、どんなのか楽しみです https://t.co/gzLFex77Ij
6年以上前
-
音楽劇「星の王子さま」兵庫公演!本日15時開演!明日は14時開演! 兵庫県立芸術文化センター阪急中ホールにて。ここは2階席もありますので当日ふらりとお越しになってもきっとお入りいただけるかと。両日ともアフタートークもございます。ついにラスト2公演!お見逃しなく!
6年以上前
-
《入荷しました!》 尾崎裕哉✨ PremiumSymphonicConcert2020 THIS IS MY ANTHEM❗️ 3/7◇兵庫県立芸術文化センター◇1枚 大須店もしくはチケットストリート から取引お願いします😍!… https://t.co/6PZEfiZJi4
6年以上前
-
県立西宮高校音楽科第33期生 二十歳を迎えて。 3月26日(木)18:00〜 兵庫県立芸術文化センター神戸女学院ホールにて!! チケット予約はこちらのアカウントのDM、チラシ記載のメールアドレスまで!! お時間ございまし… https://t.co/cWjIfzRHUc
6年以上前
-
BOOK ACT 朗読劇 「 もう一度君と踊りたい 」 兵庫県立芸術文化センター 求)2/20 19:00~ 1枚 席は気にしません! FCから一般まで全滅しました… 譲って下さる方いらっしゃいませんか? できれば当日チケットと現金手渡しがいいです。
6年以上前
-
いよいよ、最後の星🌟へ。『星の王子さま』兵庫県立芸術文化センター阪急中ホール。西宮北口駅直結!まだ星巡りしてない方、ホントにあと2回で終っちゃいますよ。ぜひ、お見逃しなく!🌟🦊🐍🌹 https://t.co/BN9X0UYuaC
6年以上前
-
BOOK ACT 朗読劇 もう一度君と踊りたい 兵庫県立芸術文化センター 2月20日 14:00 譲 G列 上手 2連 (写真 黄色) 求 〜G列 9番〜22番 2連(写真 紫色) サイドチェンジしてくださる方探してます。… https://t.co/FplY6jRxIx
6年以上前
-
BOOK ACT 02/20 19:00 兵庫県立芸術文化センター 譲ります。返金保証つきのチケットストリートから取引をお願いします! https://t.co/wRwUaCdaEV @ticketstより #朗読劇 #チケット #チケスト
6年以上前
-
【チケット一般発売開始】 ジョン・ウィリアムズ ウインドオーケストラ・コンサート 日時:2020年5月4日(月・祝) 15:00開演 指揮:西村 友 会場:兵庫県立芸術文化センター・KOBELCO大ホール… https://t.co/O1mk4LUKwf
6年以上前
-
どーも岡野と平山です。 音楽劇『星の王子さま』いよいよ最後の地、兵庫県立芸術文化センター阪急中ホールにて開幕です!!今日明日の2日間! 音も観やすさも抜群の大好きな劇場です!!当日券有り!パンフレットもオススメ✨お待ちしております… https://t.co/bVmUYcGHZf
6年以上前
-
朗読劇 BOOK ACT もう一度君と踊りたいお譲り先探しております。 【譲】兵庫県立芸術文化センター 2/20 19時公演 1階席 L〜O列 1枚 定価でのお譲りは考えておりません。 希望額明記の上DMにてご連絡お… https://t.co/PPCAEcHw7T
6年以上前
-
【音楽劇 星の王子さま】本日2/15公演のホール座席表をチェック 兵庫県立芸術文化センター阪急中ホール(中ホール/800人)https://t.co/U2b4qzW5md https://t.co/85CDXeTSDx
6年以上前
-
【兵庫芸術文化センター管弦楽団 第121回定期演奏会 ミラノフ&amp;児玉 桃 ザ・チャイコフスキー!】本日2/15公演のホール座席表をチェック 兵庫県立芸術文化センターKOBELCO大ホール(大ホール/2,001人)… https://t.co/WBs8FTZYBe
6年以上前
-
朗読劇 BOOK ACT もう一度君と踊りたい 【求】2/20 兵庫 14:00〜 兵庫県立芸術文化センター 1枚 【譲】5/10 RMPG 新潟朱鷺メッセfinal… https://t.co/ibRNwCiasf
6年以上前
-
音楽劇星の王子さまのCDがほしい。
6年以上前
-
音楽劇星の王子さまレベルで芝居に稽古時間を使ったレ・ミゼラブルが観たい。諸々違うのもわかるけど、そういうバージョンがあってもいいんじゃないかと。
6年以上前
-
朗読劇 BOOK ACT 【求】2/20 兵庫県立芸術文化センター 1階席 1連 15番〜 お譲り頂ける方はご連絡ください
6年以上前
-
2月22日(土) 19:00の部 BOOK ACT 「芸人交換日記」 (出演:小森隼/SWAY/Shizuka) 兵庫県 @ 兵庫県立芸術文化センター FC枠チケット 1連 1階 M列 ~定価 お譲り先を探しております。 詳細… https://t.co/KB7TQO7UIF
6年以上前
-
朗読劇 BOOK ACT もう一度君と踊りたい 2月20日 時間は問いません 【求】2/20 兵庫 兵庫県立芸術文化センター 1階席 上手側 1連 チケットサイト等通しての取引… https://t.co/t4UIi8CoFR
6年以上前
-
朗読劇 BOOK ACT もう一度君と踊りたい 2月20日 14時 【求】2/20 兵庫 14:00〜 兵庫県立芸術文化センター 1階席 上手側 1連 チケットサイト等通しての… https://t.co/y6UJpZYHnr
6年以上前
-
朗読劇 BOOK ACT もう一度君と踊りたい 2月20日 14時 【求】2/20 兵庫 14:00〜 兵庫県立芸術文化センター 1階席 1連 チケットサイト等通しての取引希望… https://t.co/L4ie6DHZoU
6年以上前
CoRich舞台芸術!のランキングに反映されます。
面白そうな舞台を応援しましょう!

幅広い年齢層の方々に支持される世界的ベストセラー作品「星の王子さま」。この作品を青木豪ならではの音楽劇として創造、ピアニストが薔薇役も担う独特の演出プランで展開した本作が、笠松泰洋による耳と心に残る楽曲と共に、待望の再演の機会を...
もっと読む